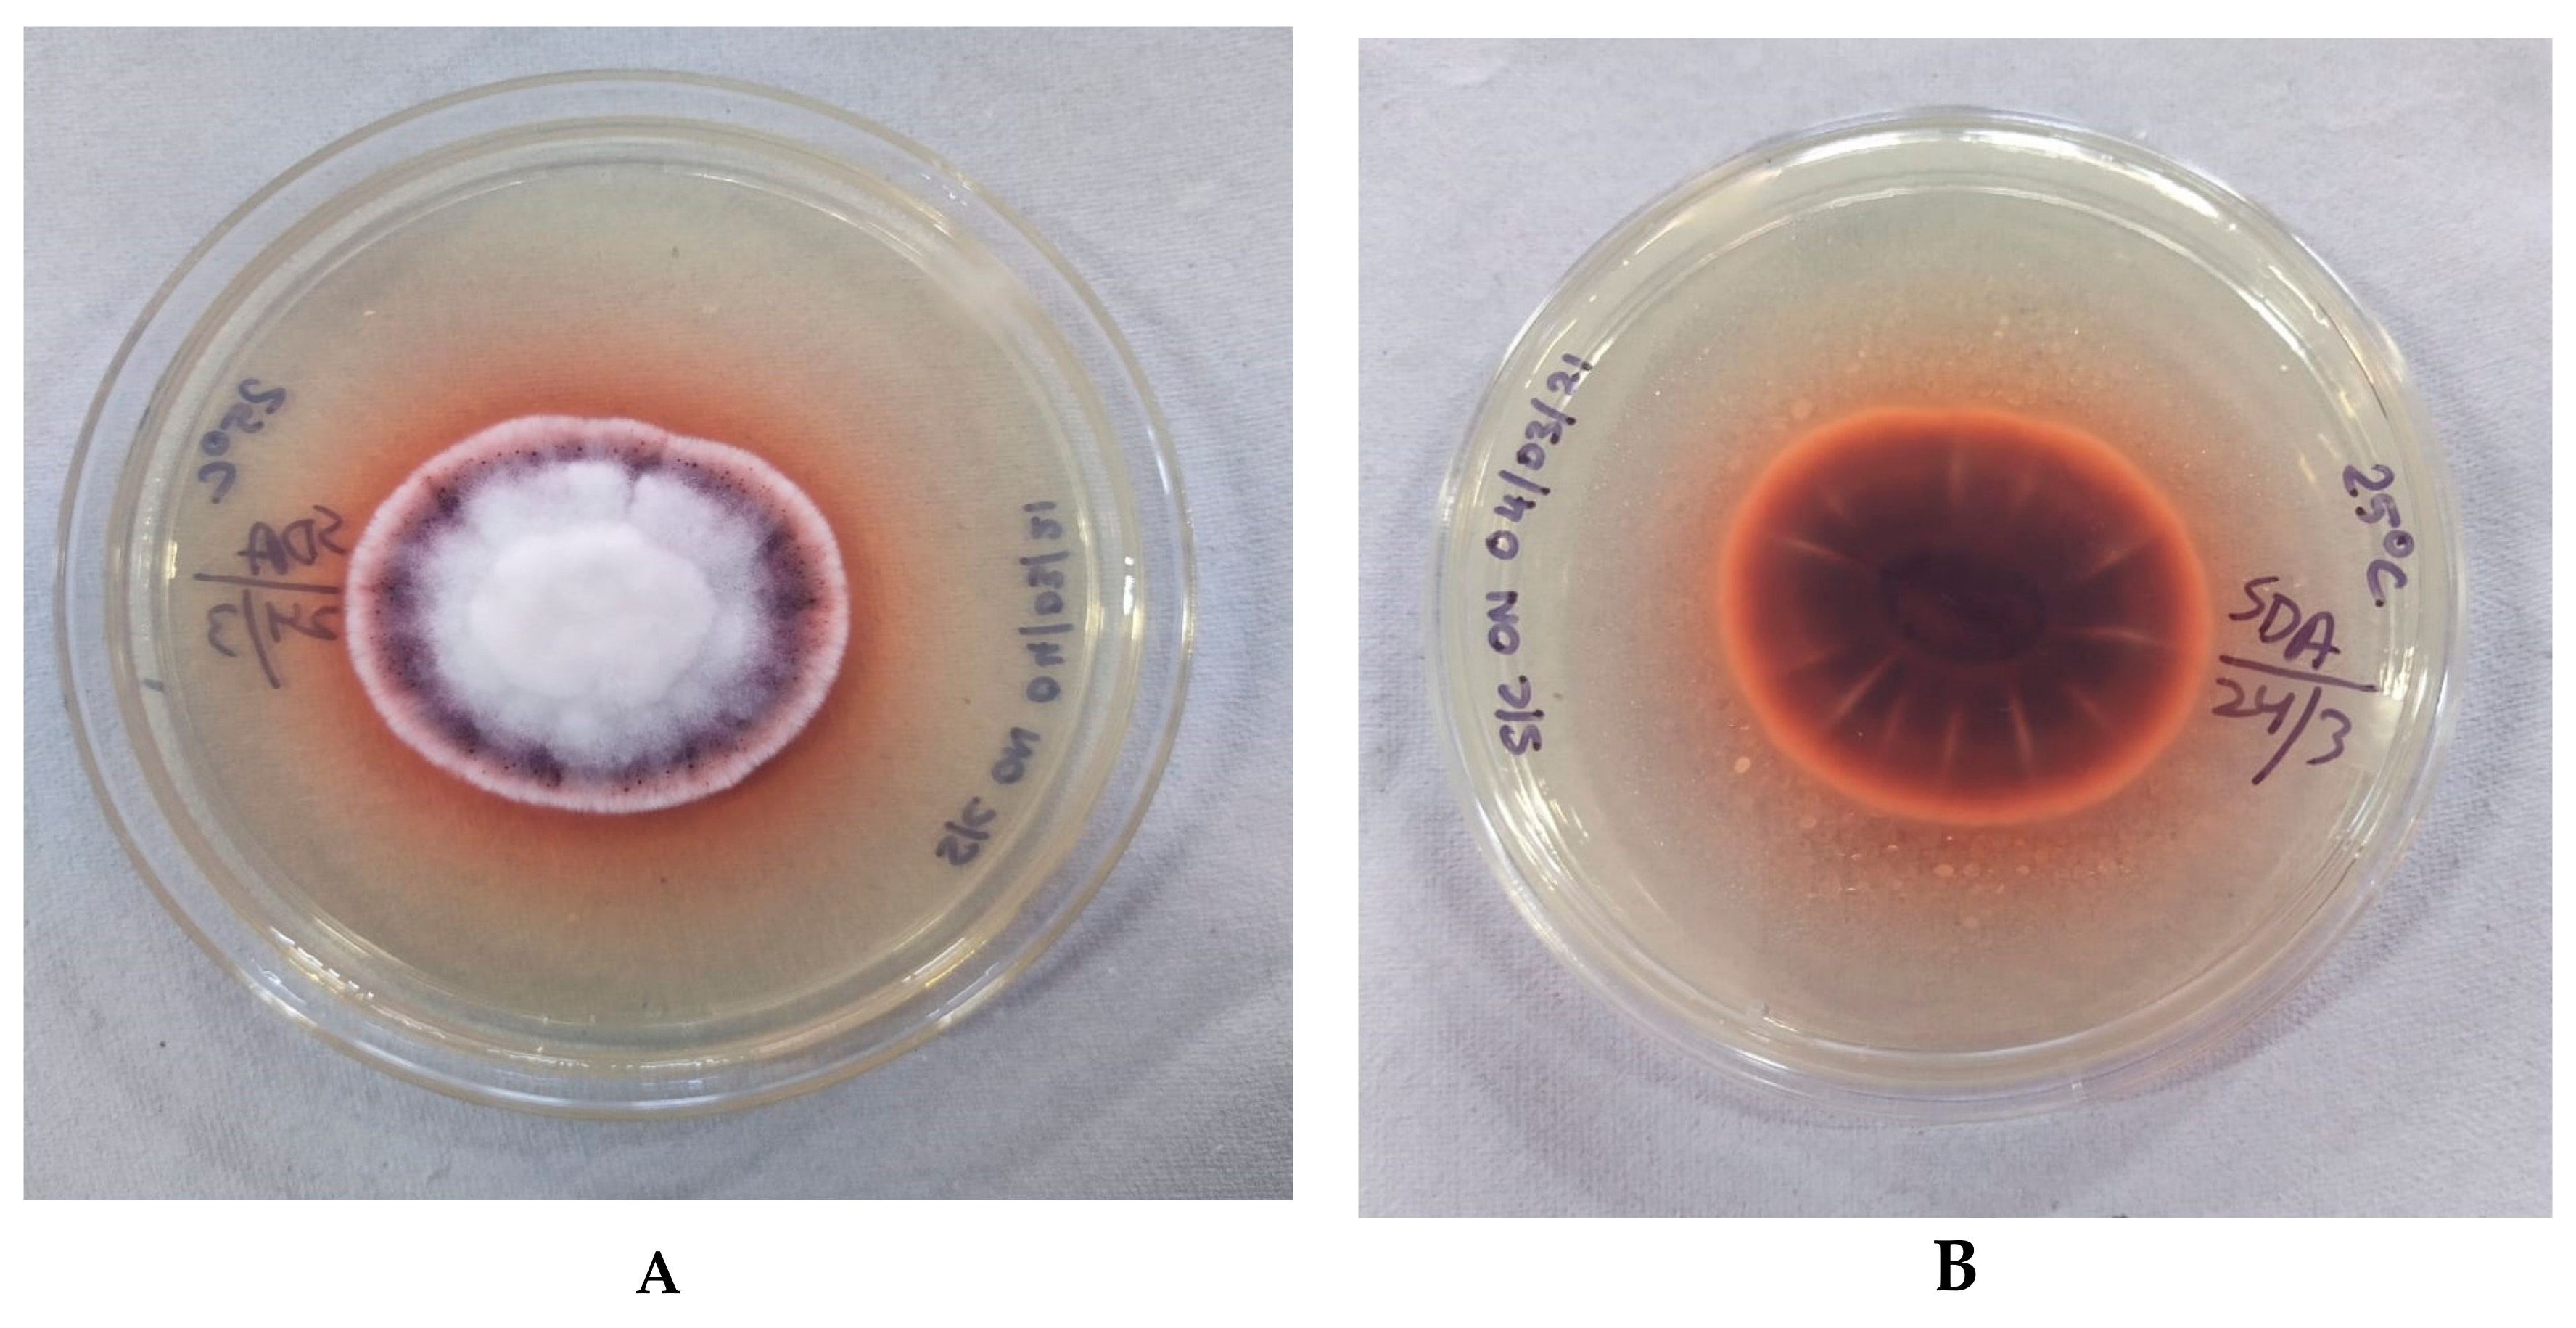
Jof 07 00889 g002 Jof 07 00889 g002

Fungal Keratitis Due to Fusarium lichenicola: A Case Report and Global Review of Fusarium lichenicola Keratitis
Abstract
1. Introduction
2. Case
3. Discussion
Author Contributions
Funding
Institutional Review Board Statement
Informed Consent Statement
Data Availability Statement
Conflicts of Interest
References
- Brown, L.; Leck, A.K.; Gichangi, M.; Burton, M.J.; Denning, D.W. The global incidence and diagnosis of fungal keratitis. Lancet Infect. Dis. 2021, 21, e49–e57. [Google Scholar] [CrossRef]
- Hoffman, J.; Burton, M.; Leck, A. Mycotic Keratitis—A Global Threat from the Filamentous Fungi. J. Fungi 2021, 7, 273. [Google Scholar] [CrossRef]
- Burton, M.J.; Pithuwa, J.; Okello, E.; Afwamba, I.; Onyango, J.J.; Oates, F.; Chevallier, C.; Hall, A.B. Microbial Keratitis in East Africa: Why are the Outcomes so Poor? Ophthalmic Epidemiol. 2011, 18, 158–163. [Google Scholar] [CrossRef] [PubMed]
- Jeng, B.H.; Gritz, D.C.; Kumar, A.B.; Holsclaw, D.S.; Porco, T.C.; Smith, S.D.; Whitcher, J.P.; Margolis, T.P.; Wong, I.G. Epidemiology of Ulcerative Keratitis in Northern California. Arch. Ophthalmol. 2010, 128, 1022–1028. [Google Scholar] [CrossRef] [PubMed]
- Alvarez-Moreno, C.A.; Cortes, J.A.; Denning, D.W. Burden of Fungal Infections in Colombia. J. Fungi 2018, 4, 41. [Google Scholar] [CrossRef] [PubMed]
- Shah, A.; Sachdev, A.; Coggon, D.; Hossain, P. Geographic variations in microbial keratitis: An analysis of the peer-reviewed literature. Br. J. Ophthalmol. 2011, 95, 762–767. [Google Scholar] [CrossRef]
- Manikandan, P.; Abdel-hadi, A.; Randhir Babu Singh, Y.; Revathi, R.; Anita, R.; Banawas, S.; Bin Dukhyil, A.A.; Alshehri, B.; Shobana, C.S.; Panneer Selvam, K.; et al. Fungal Keratitis: Epidemiology, Rapid Detection, and Antifungal Susceptibilities of Fusarium and Aspergillus Isolates from Corneal Scrapings. BioMed Res. Int. 2019, 2019, 6395840. [Google Scholar]
- Iwen, P.C.; Tarantolo, S.R.; Sutton, D.A.; Rinaldi, M.G.; Hinrichs, S.H. Cutaneous Infection Caused by Cylindrocarpon lichenicola in a Patient with Acute Myelogenous Leukemia. J. Clin. Microbiol. 2000, 38, 3375–3378. [Google Scholar] [CrossRef]
- Champa, H.; Sreeshma, P.; Prakash, P.Y.; Divya, M. Cutaneous infection with Cylindrocarpon lichenicola. Med. Mycol. Case Rep. 2013, 2, 55–58. [Google Scholar] [CrossRef]
- Chazan, B.; Colodner, R.; Polacheck, I.; Shoufani, A.; Rozenman, D.; Raz, R. Mycetoma of the Foot Caused by Cylindrocarpon lichenicola in an Immunocompetent Traveler. J. Travel Med. 2006, 11, 331–332. [Google Scholar] [CrossRef]
- Lamey, B.; Blanc, C.; Lapalu, J. Le cylindrocarbon: Nouvel agent d’intertrigo. Bull. Soc. Fr. Mycol. Med. 1985, 14, 73–76. [Google Scholar]
- Diongue, K.; Diallo, M.A.; Seck, M.C.; Ndiaye, M.; Badiane, A.S.; Diop, A.; Ndiaye, Y.D.; Ndir, O.; Ndiaye, D. Tinea pedis due to Cylindrocarpon lichenicola beginning onycholysis. Med. Mycol. Case Rep. 2016, 11, 13–15. [Google Scholar] [CrossRef]
- Sharma, R.; Farmer, C.K.; Gransden, W.R.; Ogg, C.S. Peritonitis in continuous ambulatory peritoneal dialysis due to Cylindrocarpon lichenicola infection. Nephrol. Dial. Transplant. 1998, 13, 2662–2664. [Google Scholar] [CrossRef][Green Version]
- Lizano-Calvo, M.; Brenes, A.; Gomez-Alpizar, L. First case of onychomycosis caused by Cylindrocarpon lichenicola in an immunosuppressed patient in Costa Rica. Acta Médica Costarricense 2013, 44, 199–204. [Google Scholar]
- Pflugfelder, S.C.; Flynn, H.W.; Zwickey, T.A.; Forster, R.K.; Tsiligianni, A.; Culbertson, W.W.; Mandelbaum, S. Exogenous Fungal Endophthalmitis. Ophthalmology 1988, 95, 19–30. [Google Scholar] [CrossRef]
- James, E.; Orchard, K.; McWhinney, P.; Warnock, D.; Johnson, E.; Mehta, A.; Kibbler, C. Disseminated infection due to Cylindrocarpon lichenicola in a patient with acute myeloid leukemia. J. Infect. 1997, 34, 65–67. [Google Scholar] [CrossRef]
- Rodriguez Villalobos, H.; Georgala, A.; Beguin, H.; Heymans, C.; Pye, G.; Crokaert, F.; Aoun, M. Disseminated Infection due to Cylindrocarpon (Fusarium) lichenicola in a Neutropenic Patient with Acute Leukaemia: Report of a Case and Review of the Literature. Eur. J. Clin. Microbiol. Infect. Dis. Off. Publ. Eur. Soc. Clin. Microbiol. 2003, 22, 62–65. [Google Scholar] [CrossRef] [PubMed]
- Laverde, S.; Moncada, L.H.; Restrepo, A.; Vera, C.L. Mycotic keratitis; 5 cases caused by unusual fungi. Med. Mycol. 1973, 11, 119–123. [Google Scholar] [CrossRef] [PubMed]
- Matsumoto, T.; Masaki, J.; Okabe, T. Cylindrocarpon Tonkinense: As A Cause Of Keratomycosis. Trans Brit Mycol Soc. 1979, 72, 503–504. [Google Scholar] [CrossRef]
- Mangiaterra, M.; Giusiano, G.; Smilasky, G.; Zamar, L.; Amado, G.; Vicentín, C. Keratomycosis caused by Cylindrocarpon lichenicola. Med. Mycol. 2001, 39, 143–145. [Google Scholar] [CrossRef][Green Version]
- Kaliamurthy, J.; Jesudasan, C.A.N.; A Prasanth, D.; A Thomas, P. Keratitis due to Cylindrocarpon lichenicola. J. Postgrad. Med. 2006, 52, 155–157. [Google Scholar]
- Kaben, U.; Beck, R.; Tintelnot, K. Keratomykose durch Cylindrocarpon lichenicola. Keratomycosis due to Cylindrocarpon lichenicola. Mycoses 2006, 49, 9–13. [Google Scholar] [CrossRef]
- Mitra, A.; Savant, V.; Aralikatti, A.; Dean, S.; Shah, S. The Use of Voriconazole in the Treatment of Cylindrocarpon Keratomycosis. Cornea 2009, 28, 217–218. [Google Scholar] [CrossRef]
- Irek, E.; Obadare, T.O.; Udonwa, P.A.; Laoye, O.; Abiri, O.V.; Adeoye, A.O.; Aboderin, A. Cylindrocarpon lichenicola keratomycosis in Nigeria: The challenge of limited access to effective antimicrobials. Afr. J. Lab. Med. 2017, 6, 3. [Google Scholar] [CrossRef][Green Version]
- Gaujoux, T.; Borsali, E.; Gavrilov, J.-C.; Touzeau, O.; Goldschmidt, P.; Despiau, M.-C.; Chaumeil, C.; Laroche, L.; Borderie, V. Fungal keratitis caused by Cylindrocarpon lichenicola. J. Fr. Ophtalmol. 2012, 35, 356.e1-5. [Google Scholar] [CrossRef]
- Ghosh, A.; Kaur, H.; Gupta, A.; Singh, S.; Rudramurthy, S.M.; Gupta, S.; Chakrabarti, A. Emerging Dematiaceous and Hyaline Fungi Causing Keratitis in a Tertiary Care Centre from North India. Cornea 2020, 39, 868–876. [Google Scholar] [CrossRef]
- Shenoy, M.S.; Nayak, R.R.; Pai, V.; Bhat, K.A. Mycotic keratitis due to Cylindrocarpon lichenicola: Successful salvage of the eye. Indian J. Med. Microbiol. 2020, 38, 472–474. [Google Scholar]
- Dongyou, L. Molecular Detection of Human Fungal Pathogens-CRC Press (2011).pdf | Fungus. Available online: https://www.scribd.com/document/442878807/Dongyou-Liu-Molecular-Detection-of-Human-Fungal-Pathogens-CRC-Press-2011-pdf (accessed on 28 May 2021).
- Punja, Z.K.; Ni, L.; Roberts, A. The Fusarium solani species complex infecting cannabis (Cannabis sativa L., marijuana) plants and a first report of Fusarium (Cylindrocarpon) lichenicola causing root and crown rot. Can. J. Plant Pathol. 2021, 43, 567–581. [Google Scholar] [CrossRef]
- Summerbell, R.C.; Schroers, H.-J. Analysis of Phylogenetic Relationship of Cylindrocarpon lichenicola and Acremonium falciforme to the Fusarium solani Species Complex and a Review of Similarities in the Spectrum of Opportunistic Infections Caused by These Fungi. J. Clin. Microbiol. 2002, 40, 2866–2875. [Google Scholar] [CrossRef]
- Prajna, N.V.; Krishnan, T.; Rajaraman, R.; Patel, S.; Shah, R.; Srinivasan, M.; Devi, L.; Das, M.; Ray, K.J.; O’Brien, K.S.; et al. Adjunctive Oral Voriconazole Treatment of Fusarium Keratitis: A Secondary Analysis from the Mycotic Ulcer Treatment Trial II. JAMA Ophthalmol. 2017, 135, 520–525. [Google Scholar] [CrossRef] [PubMed]
- Sharma, N.; Singhal, D.; Maharana, P.K.; Sinha, R.; Agarwal, T.; Upadhyay, A.D.; Velpandian, T.; Satpathy, G.; Titiyal, J.S. Comparison of Oral Voriconazole Versus Oral Ketoconazole as an Adjunct to Topical Natamycin in Severe Fungal Keratitis: A Randomized Controlled Trial. Cornea 2017, 36, 1521–1527. [Google Scholar] [CrossRef] [PubMed]
- Subramanian, C.V. Hyphomycetes; An Account of Indian Species, except Cercosporae; Indian Council of Agricultural Research: New Delhi, India, 1971. [Google Scholar]

| Case Number | Year Isolated | Place | Patient Age (in Years) | Gender | History of Trauma | Antifungal Therapy | Therapeutic Keratoplasty | Outcome | References |
|---|---|---|---|---|---|---|---|---|---|
| 1 | 1971 | Venezuela | 46 | Male | Muddy water | Topical Pimaricin 5% | Conjunctival flap | Improved | Laverde et al. [18] |
| 2 | 1979 | Japan | 55 | Female | Muddy water | Amphotericin B Clotrimazole 5 weeks both topical and systemic | No | Corneal perforation | Matsumoto et al. [19] |
| 3 | 2001 | Formosa, Argentina | 30 | Male | No | Topical natamycin 5% | No | Phthisis bulbi | Mangiaterra et al. [20] |
| 4 | 2006 | India | 56 | Male | Vegetative material | Topical natamycin 5% | Yes | Phthisis bulbi | Kaliamurthy J [21] |
| 5 | 2006 | Germany | 61 | Male | No (history of contact with Clematis plant) |
Voriconazole 12 weeks both systemic and topical | No | Improved | Kaben et al. [22] |
| 6 | 2006 | Germany | 71 | Male | No |
Topical Amphotericin B 6 weeks | No | Improved | Kaben et al. [22] |
| 7 | 2009 | United Kingdom | 56 | Female | No (keen Gardener, soft contact lens wearer) | Natamycin 5% drops every 2 h, oral voriconazole 200 mg twice daily | No | Complete resolution of ulcer with stromal scar | Mitra A et al. [23] |
| 8 | 2017 | Nigeria | 67 | Male | No (farmer) | Topical natamycin (5%), oral fluconazole (200 mg) daily | No | Corneal scar VA: no improvement (hand movements only) | Irek et al. [24] |
| 9 | 2012 | France | 67 | Female | Trauma with cloth fabric | Voriconazole, Amphotericin B | Yes | No recurrence after 1 year | Gaujoux T et al. [25] |
| 10 | 1 case in a retrospective review (2005–2011) | Chandigarh, India | 32 | Male | Vegetative Material | Oral Itraconazole, natamycin 5% | No | Vascularized corneal opacity | Ghosh et al. [26] |
| 11 | 2020 | Kerala, India | 60 | Female | No | Oral ketoconazole, voriconazole, natamycin 5% | Yes | Stable with opaque graft requiring repeat TK | Shenoy et al. [27] |
| 12 | 2021 * | Bihar, India | 28 | Male | Trauma with foreign body while driving a motorbike | Natamycin 5% topical, ketoconazole 200 mg systemic | Yes | Lost to follow up | Halim et al. * |
Publisher’s Note: MDPI stays neutral with regard to jurisdictional claims in published maps and institutional affiliations. |
© 2021 by the authors. Licensee MDPI, Basel, Switzerland. This article is an open access article distributed under the terms and conditions of the Creative Commons Attribution (CC BY) license (https://creativecommons.org/licenses/by/4.0/).
Share and Cite
Halim, I.; Singh, P.; Sarfraz, A.; Kokkayil, P.; Pati, B.K.; Thakuria, B.; Raj, A. Fungal Keratitis Due to Fusarium lichenicola: A Case Report and Global Review of Fusarium lichenicola Keratitis. J. Fungi 2021, 7, 889. https://doi.org/10.3390/jof7110889
Halim I, Singh P, Sarfraz A, Kokkayil P, Pati BK, Thakuria B, Raj A. Fungal Keratitis Due to Fusarium lichenicola: A Case Report and Global Review of Fusarium lichenicola Keratitis. Journal of Fungi. 2021; 7(11):889. https://doi.org/10.3390/jof7110889
Chicago/Turabian StyleHalim, Isra, Prabhakar Singh, Asim Sarfraz, Prathyusha Kokkayil, Binod Kumar Pati, Bhaskar Thakuria, and Amit Raj. 2021. "Fungal Keratitis Due to Fusarium lichenicola: A Case Report and Global Review of Fusarium lichenicola Keratitis" Journal of Fungi 7, no. 11: 889. https://doi.org/10.3390/jof7110889
APA StyleHalim, I., Singh, P., Sarfraz, A., Kokkayil, P., Pati, B. K., Thakuria, B., & Raj, A. (2021). Fungal Keratitis Due to Fusarium lichenicola: A Case Report and Global Review of Fusarium lichenicola Keratitis. Journal of Fungi, 7(11), 889. https://doi.org/10.3390/jof7110889

